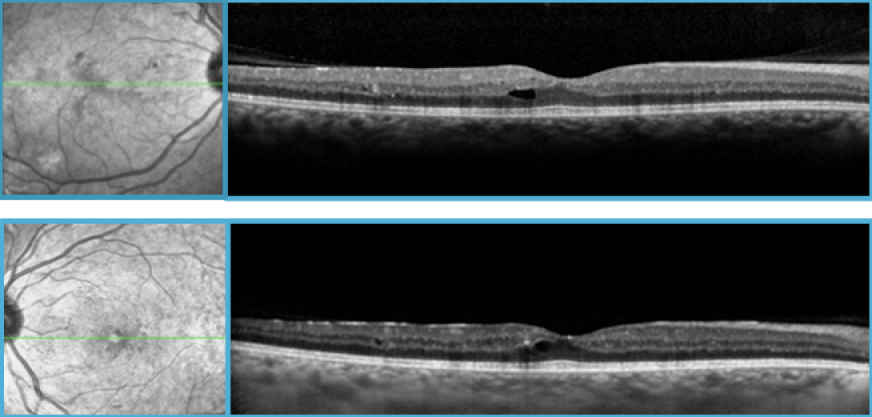

Serous retinal detachment following panretinal photocoagulation (PRP) using Pattern Scan Laser (PASCAL) photocoagulator
Georges Azar 1Benjamin Wolff 1
Pierre-Loïc Cornut 2
Martine Mauget-Faÿsse 3
1 Retinal Department, Rothschild Ophthalmologic Foundation, Paris, France
2 Edouard Herriot Hospital, Lyon, France
3 Centre Rabelais, Lyon, France
Abstract
Objective: To report a case of serous retinal detachment after Pattern Scan Laser (PASCAL) treatment in a diabetic woman.
Methods: A 34-year-old diabetic woman presented with florid diabetic retinopathy after a miscarriage during the 20th week of pregnancy. Her Best Corrected Visual Acuity (BCVA) was 20/40 right eye (OD) and 20/30 left eye (OS). Fundus exam showed multiple microaneurysms, large blot hemorrhages and venous dilation both eyes (OU). Fundus fluorescein angiography (FFA) revealed large areas of capillary nonperfusion and panretinal neovascularisation in all quadrants OU. Macular Spectral-Domain Optical Coherence Tomography scan (SD-OCT) did not show any foveal thickening. Panretinal photocoagulation (PRP) was immediately performed OU during the same day.
Results: Two days after PASCAL treatment, her BCVA decreased to 20/80 OU and worsened to Count Fingers (CF) during the following days. Fundus exam revealed an extensive serous retinal detachment confirmed on SD-OCT. 2 sub-conjunctival injections of 0.1 ml Betamethasone were done OU. One month later, BCVA improved to 20/30 and SD-OCT confirmed regression of retinal detachment.
Conclusions: PASCAL is considered to be a safe treatment, but one has to be aware of its potential side effects. It has to be used with caution in pregnant women.
Keywords
serous retinal detachment, florid diabetic retinopathy, PASCAL treatment
Introduction
The Pattern Scan Laser (PASCAL) photocoagulator (OptiMedia, Santa Clara, California) was first introduced in 2005 for the treatment of various retinal vascular diseases [1]. It automates retinal photocoagulation using a brief pulse with rapid raster application of multiple spots, which allows shorter treatment delivery time [2]. It offers greater speed and comfort than traditional argon laser for patients receiving panretinal photocoagulation (PRP), and is widely considered as a safe treatment [3]. However, we now report the first case of a patient who developed large serous retinal detachment after PASCAL treatment.
Case description
A 34-year-old woman with long-standing insulin-dependent diabetes mellitus (IDDM), presented with florid diabetic retinopathy after a miscarriage during the 20th week of pregnancy. Her blood pressure was always within normal limits, and there was no history of pre-eclampsia, eclampsia or any other vascular diseases as noted with her biological and clinical exam. According to her obstetrician, the miscarriage was due to poor control of her diabetes.
On presentation, Best Corrected Visual Acuity (BCVA) was 20/40 right eye (OD) and 20/30 left eye (OS). Slit lamp examination was normal in both eyes (OU). Fundus abnormalities included multiple microaneurysms in the posterior pole, large blot hemorrhages and venous dilation OU. Fundus fluorescein angiogram (FFA) showed large areas of capillary nonperfusion and dye leakage from preretinal neovascularisation in all quadrants OU. There was no angiographic evidence of macular ischemia or leakage. Macular spectral-domain optical coherence tomography scan (SD-OCT) showed one small intraretinal microcyst without significant macular thickening or foveal involvement OU (Figure 1 [Fig. 1]).
Figure 1: SD-OCT at presentation OU showing a small intraretinal microcyst with no significant macular thickness. No foveal involvment is shown.
PRP with PASCAL photocoagulator was immediately started and completed OU the same day, using classic parameters as previously described [4]. 2000 laser spots of 200 microns and moderate intensity producing retinal blanching, using the Mainster PRP 165 laser lens were applied. Two days later, our patient presented with a rapid decrease in her vision. Her BCVA was 20/80 OU.
Fundus examination showed extensive pan-retinal laser burns with large perimacular serous retinal detachment at the level of the temporal superior arcade as confirmed on SD-OCT (Figure 2 [Fig. 2]). FFA revealed a marked reversal of microvascular lesions and leakage. During the following days, her vision further dropped to Count Fingers (CF) due to worsening of her retinal detachment. 2 sub-conjunctival injections of 0.1 ml Betamethasone were done 24 hours apart on each eye. One month later, her BCVA improved to 20/30. SD-OCT confirmed regression of retinal detachment.
Figure 2: SD-OCT showing a large serous retinal detachment (SRD) at the level of the temporal superior arcade (arrow) OD 2 days following PRP with the PASCAL photocoagulator (A). A similar image was seen in the fellow eye (B). 
Discussion
PASCAL is widely considered to be a safe and effective treatment in various retinal diseases. However, one has to be aware of its potential side effects. In this particular patient with very poor controlled diabetes, an extensive PASCAL treatment was done in order to prevent any hemorrhage, tractional retinal detachment and neovascular glaucoma, rendering future laser difficult or unresponsive. However, this may have exaggerated the effect of intra-vitreal growth factors already abundantly present in this 34-year-old woman who just had her miscarriage. Even if the pulse duration is shorter, this technique still delivers energy and heat to the retinal pigment epithelium and may be responsible for transient rupture of the blood-retinal barrier.
Conclusion
Long terms complications and eventual recurrences have to be carefully observed when using the PASCAL photocoagulator. It has to be used with caution in pregnant women. The maximal tolerated spot count per session as well as other laser parameters used to control proliferative diabetic retinopathy are yet to be determined, and should always be weighted to potential side effects encountered.
Notes
Competing interests
The authors declare that they have no competing interests.
References
[1] Blumenkranz MS, Yellachich D, Andersen DE, Wiltberger MW, Mordaunt D, Marcellino GR, Palanker D. Semiautomated patterned scanning laser for retinal photocoagulation. Retina. 2006 Mar;26(3):370-6. DOI: 10.1097/00006982-200603000-00024[2] Muqit MM, Marcellino GR, Henson DB, Young LB, Patton N, Charles SJ, Turner GS, Stanga PE. Single-session vs multiple-session pattern scanning laser panretinal photocoagulation in proliferative diabetic retinopathy: The Manchester Pascal Study. Arch Ophthalmol. 2010 May;128(5):525-33. DOI: 10.1001/archophthalmol.2010.60
[3] Sanghvi C, McLauchlan R, Delgado C, Young L, Charles SJ, Marcellino G, Stanga PE. Initial experience with the Pascal photocoagulator: a pilot study of 75 procedures. Br J Ophthalmol. 2008 Aug;92(8):1061-4. DOI: 10.1136/bjo.2008.139568
[4] Muqit MM, Sanghvi C, McLauchlan R, Delgado C, Young LB, Charles SJ, Marcellino GR, Stanga PE. Study of clinical applications and safety for Pascal((R)) laser photocoagulation in retinal vascular disorders. Acta Ophthalmol. 2010 Feb 16;88:1-7. DOI: 10.1111/j.1755-3768.2009.01854.x



